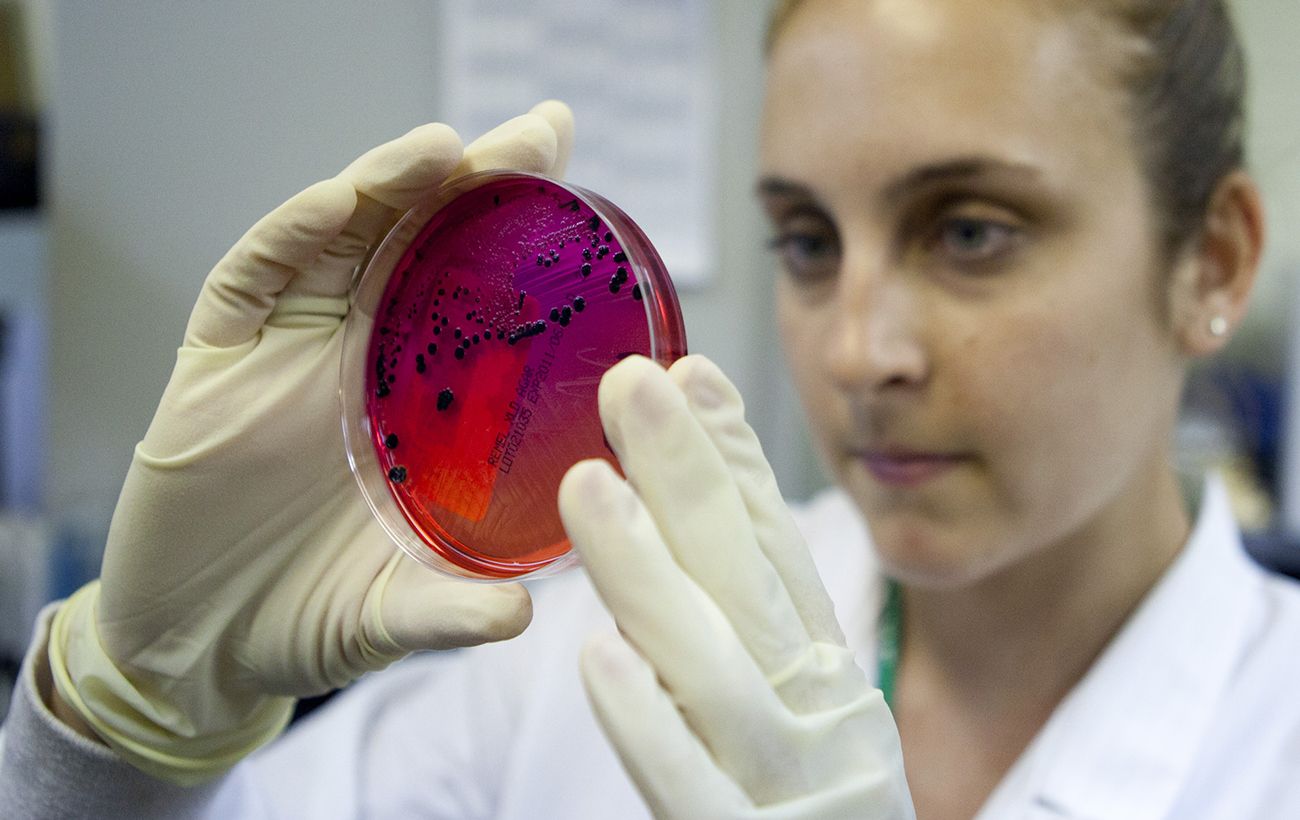

Во Львове вспышка сальмонеллеза в детсаду, дети попали в больницу
Медики госпитализировали восемь пострадавших малышей в инфекционный стационар Во Львове зафиксировали вспышку опасной инфекции в одном из детских садов города. По состоянию на 7 мая восемь малышей уже находятся в больнице. rbc.ua »